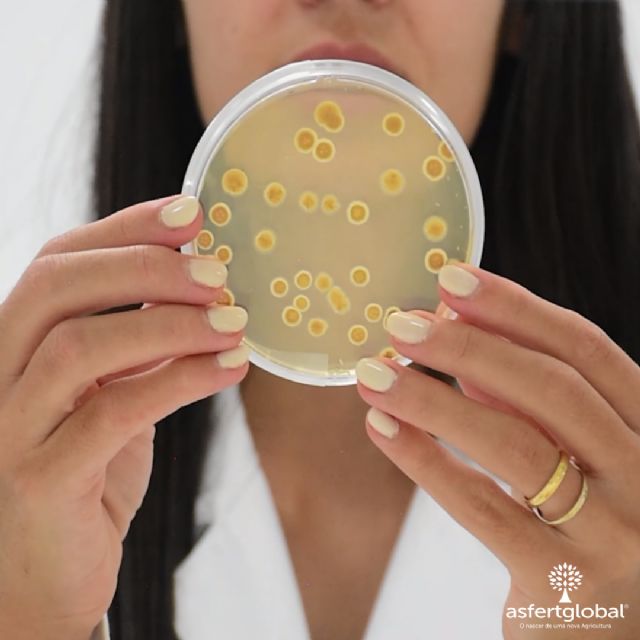
Asfertglobal alcanza un nuevo récord de ventas en 2022 - 2, Foto 2

Asfertglobal aumenta su facturación un 35% y el número de colaboradores un 20%, centrándose principalmente en los mercados Norteamérica, Europa del Este y Sudáfrica
Asfertglobal, multinacional portuguesa especializada en el desarrollo y comercialización de biofertilizantes, bioestimulantes y productos de biocontrol, mantuvo su ritmo de crecimiento, cerrando 2022 con un incremento del 35% en su facturación respecto al año anterior, y un aumento del 10% en el número de colaboradores, no sólo en Portugal, sino también en México y España.
Durante 2022, Asfertglobal reforzó su posición en la escena nacional e internacional con un aumento de las ventas en mercados clave para la agricultura mundial, como Estados Unidos, México, Turquía, Sudáfrica, Francia, Italia y Portugal.
Este crecimiento también fue el resultado de una mayor demanda de biofertilizantes, con un aumento del 50% en las ventas de los productos Kiplant Allgrip y Kiplant iNmass, y de soluciones de biocontrol como Kiplant Essence, Microil y Kiplant VS-04. Estas soluciones han sido la respuesta a los grandes retos de la agricultura, soluciones innovadoras y tecnológicas que ayudan a practicar una agricultura más sostenible y sin residuos.